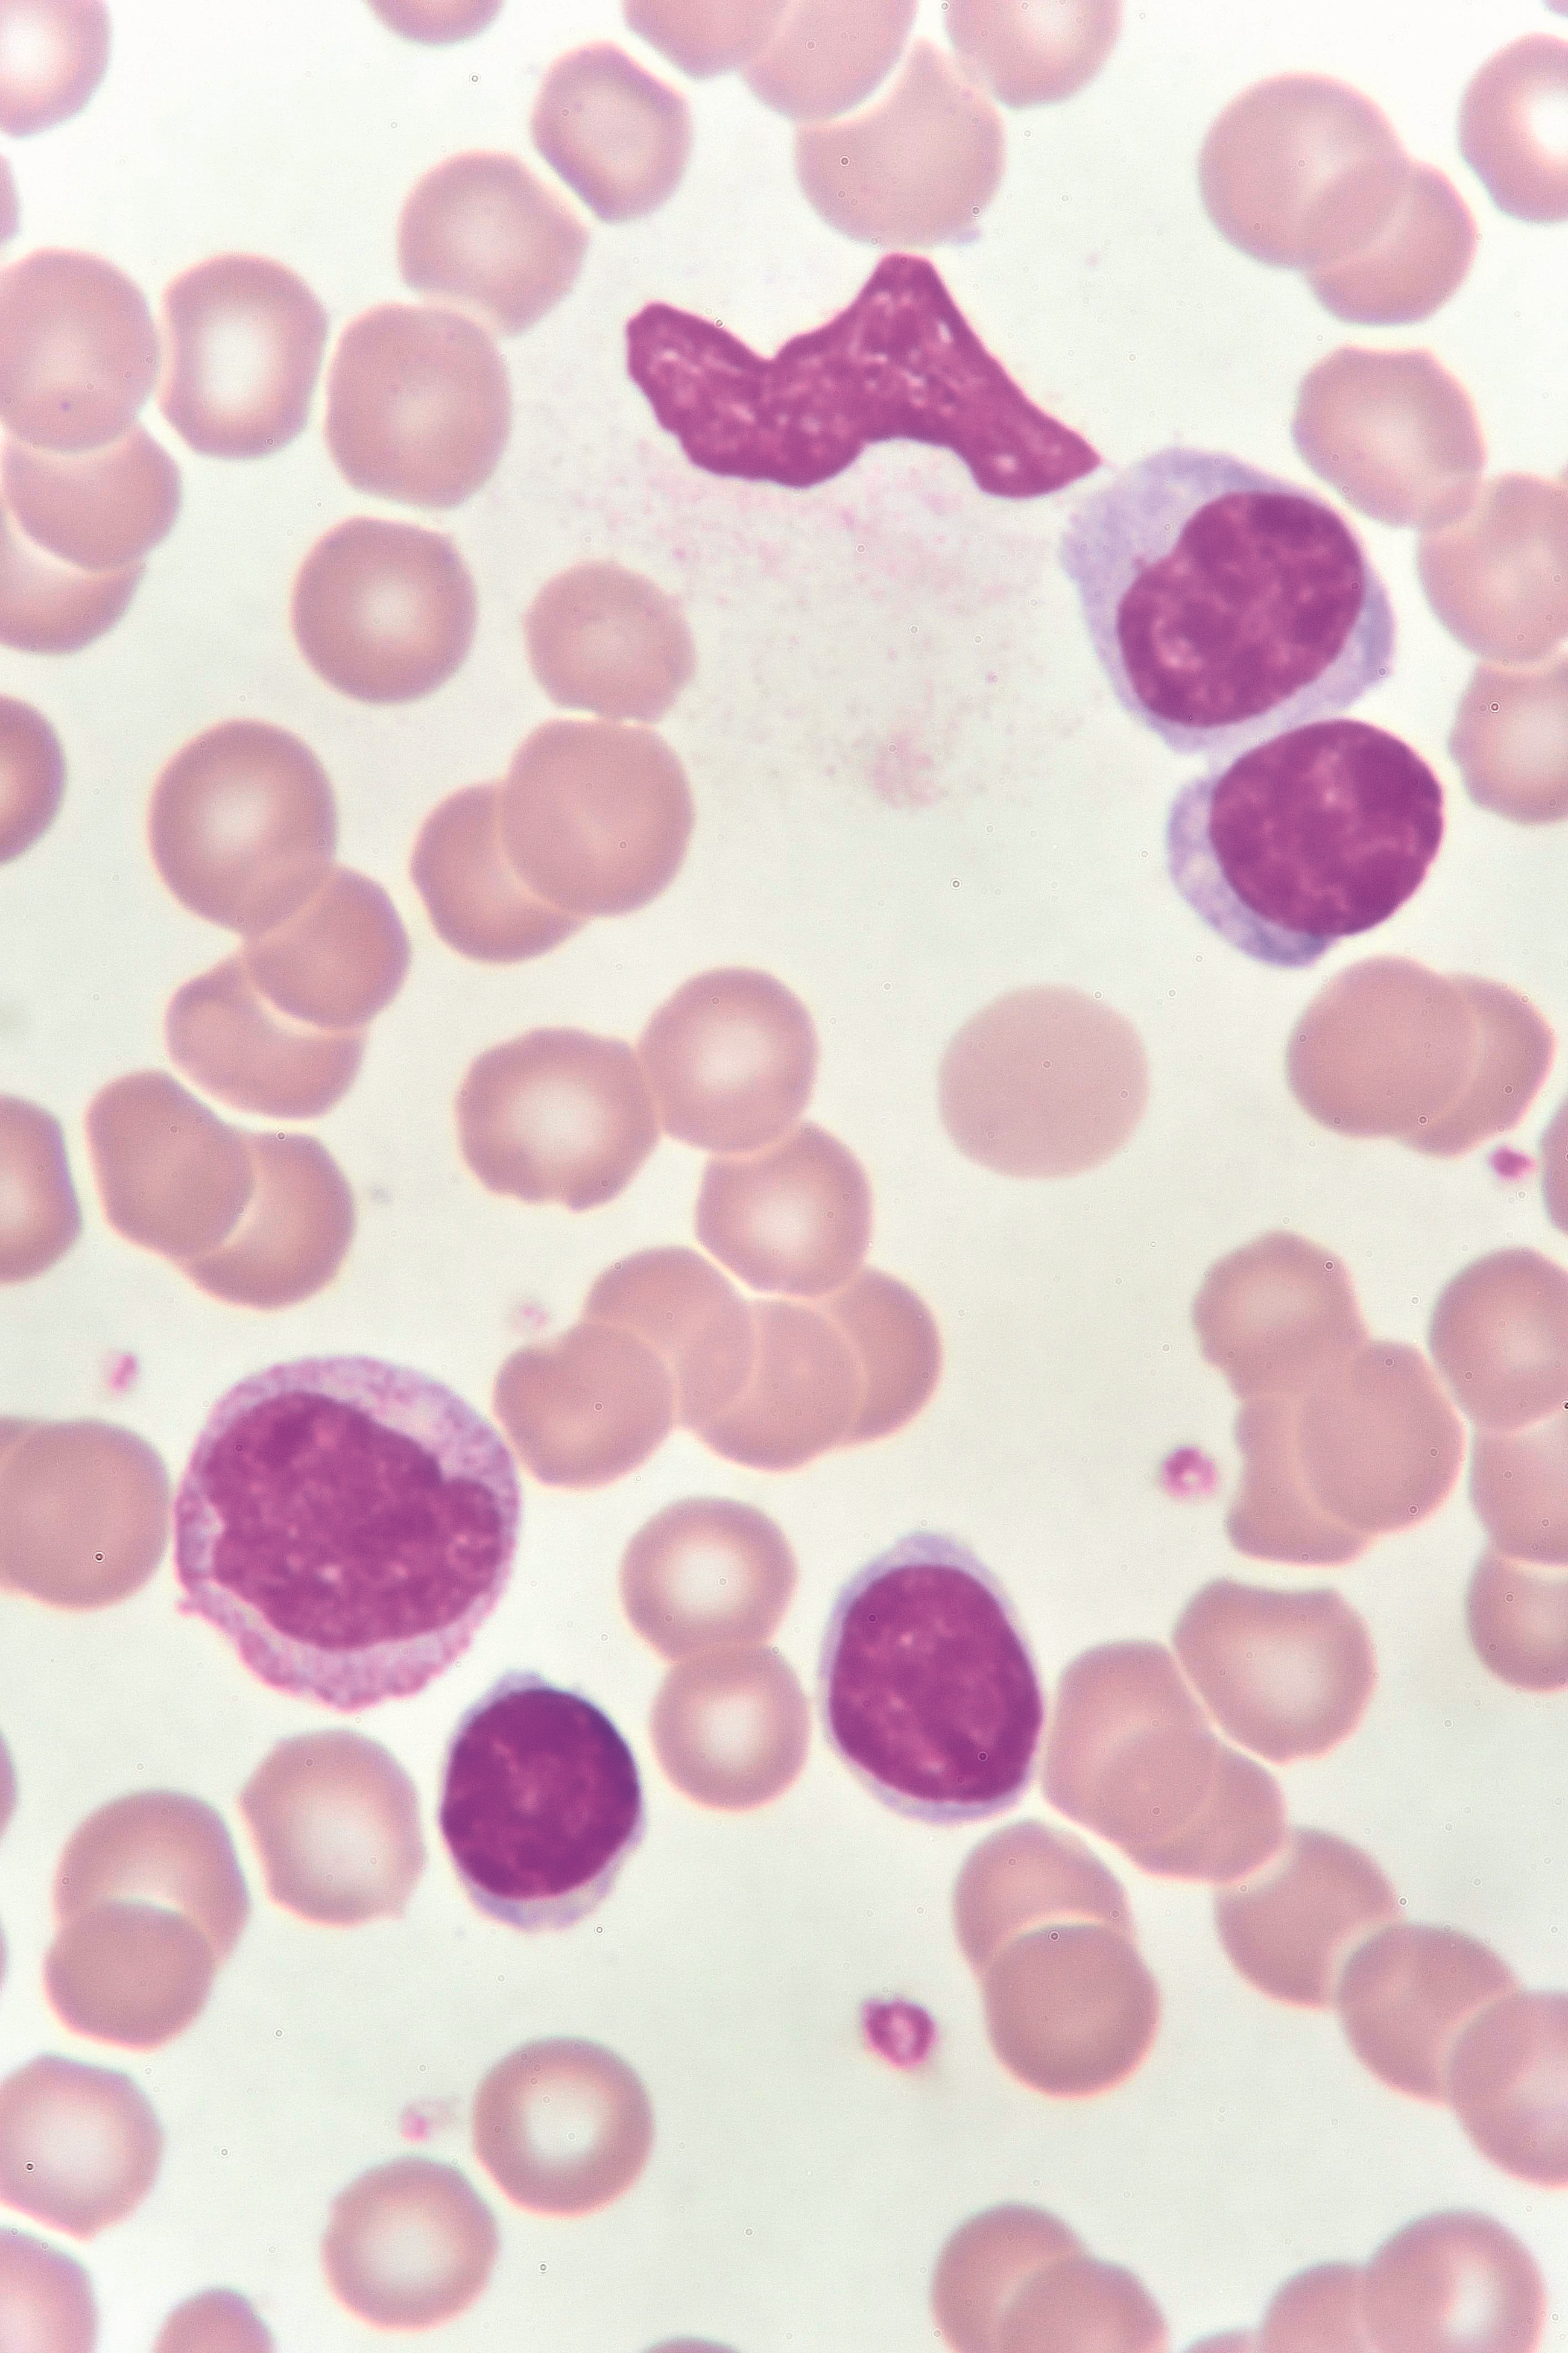

Skip Nav Destination
JAK1/2 inhibitor ruxolitinib for the treatment of systemic chronic active Epstein-Barr virus disease: a phase 2 study
Addition of navitoclax to ruxolitinib for patients with myelofibrosis with progression or suboptimal response
A phase 1 study of interleukin-15 in combination with mogamulizumab in relapsed and refractory T-cell malignancies
Low platelet counts and low CD4/CD8 ratios at apheresis increase the risk of CAR T-cell manufacturing failure in myeloma
Issue Archive
Table of Contents
SYSTEMATIC REVIEW
BASIC MECHANISMS OF NEOPLASIA
CLINICAL TRIALS AND OBSERVATIONS
JAK1/2 inhibitor ruxolitinib for the treatment of systemic chronic active Epstein-Barr virus disease: a phase 2 study
Clinical Trials & Observations
Yu Uemura,Masahide Yamamoto,Masataka Ishimura,Hirokazu Kanegane,Akihisa Sawada,Akihiro Hirakawa,Ken-Ichi Imadome,Mayumi Yoshimori,Masashi Nagata,Kouhei Yamamoto,Norio Shimizu,Ryuji Koike,Ayako Arai
Addition of navitoclax to ruxolitinib for patients with myelofibrosis with progression or suboptimal response
Clinical Trials & Observations
Naveen Pemmaraju,Tim C.P. Somervaille,Francesca Palandri,Claire Harrison,Rami S. Komrokji,Andrew Perkins,Rosa M. Ayala Diaz,David Lavie,Akihiro Tomita,Yang Feng,Qin Qin,Jason Harb,Akshanth R. Polepally,Jalaja Potluri,Jacqueline S. Garcia
A phase 1 study of interleukin-15 in combination with mogamulizumab in relapsed and refractory T-cell malignancies
Clinical Trials & Observations
Max J. Gordon,Sigrid Dubois,Milos D. Miljkovic,Samuel Ng,Bonita Bryant,Rahul Lakhotia,Christopher Melani,Stefania Pittaluga,Kevin Conlon,Thomas Waldmann,Louis M. Staudt,Wyndham H. Wilson,Mark Roschewski
LYMPHOID NEOPLASIA
Real-world characteristics, treatment patterns, and outcomes of patients with 2 or more LOTs for CLL/SLL in the United States
Matthew S. Davids,Jacob Ambrose,Enrico de Nigris,Jennifer Prescott,Siyang Leng,Mohammed Z. H. Farooqui,Shravanthi R. Gandra,Christina M. Zettler,Laura L. Fernandes,Ching Kun Wang,Mazyar Shadman
Diagnostic genomic analysis is prognostic in AYA patients with ALL treated on an MRD-stratified pediatric protocol
David T. Yeung,Laura N. Eadie,Jacqueline Rehn,Susan L. Heatley,Barbara J. McClure,Elyse C. Page,Caitlin E. Schutz,Michael P. Osborn,Toby Trahair,Rosemary Sutton,Michelle J. Henderson,John Kwan,Sally Mapp,Luciano Dalla-Pozza,Kenneth Bradstock,Matthew Greenwood,Deborah L. White
Single-cell and spatial characterization of plasmablast-like lymphoma cells in primary central nervous system lymphoma
Hiroki Kobayashi,Ryota Chijimatsu,Yusuke Naoi,Yoshihiro Otani,Ryo Mizuta,Kentaro Fujii,Joji Ishida,Hiroyuki Murakami,Hideki Ujiie,Kazuhiro Ikeuchi,Tomohiro Urata,Keisuke Seike,Hideaki Fujiwara,Noboru Asada,Nobuharu Fujii,Ken-ichi Matsuoka,Yasuharu Sato,Yoshinobu Maeda,Daisuke Ennishi
Loss of p53 impairs death receptor expression and confers resistance to CD19 CAR T-cell therapy in BCP-ALL
Willem P. J. Cox,Noël M. M. Dautzenberg,Linde Dekker,Tesa Klenovsek,Annelisa M. Cornel,Marliek van Hoesel,Dorette S. van Ingen Schenau,Reno S. Bladergroen,Roland P. Kuiper,Laurens T. van der Meer,Friso G. Calkoen,Stefan Nierkens,Frank N. van Leeuwen
Low platelet counts and low CD4/CD8 ratios at apheresis increase the risk of CAR T-cell manufacturing failure in myeloma
Clinical Trials & Observations
Tomoyasu Jo,Kyoko Yoshihara,Masaki Ri,Nobuhiro Tsukada,Naoya Mimura,Keiko Fujii,Kentaro Fukushima,Shin-Ichiro Fujiwara,Yuji Shimura,Kyoko Haraguchi,Koji Kato,Atsushi Satake,Akiyo Yoshida,Rikio Suzuki,Junko Ikemoto,Keita Iwaki,Wataru Takeda,Noboru Yonetani,Ryuji Tanosaki,Minami Yamada-Fujiwara,Kaoru Kahata,Tokiko Nagamura-Inoue,Satoshi Yoshihara,Yasuyuki Arai
TRANSLATIONAL RESEARCH
RESEARCH LETTERS
Outcomes of follicular lymphoma with leukemic phase in the modern era: results from a large multicenter study
Asaad Trabolsi,Sunwoo Han,Narendranath Epperla,Kaitlin Annunzio,Firas Baidoun,Muhamad Alhaj Moustafa,Dan Morgenstern-Kaplan,Peter Doukas,Frederique St-Pierre,Brittany McCall,Lindsey Fitzgerald,Jose Sandoval-Sus,Shivani Dalal,Isildinha M. Reis,Jennifer Rose Chapman-Fredricks,Seo-Hyun Kim,Cherry Au,Natalie B. Otto,Khaled Alhamad,Thomas Ollila,Reem Karmali,Geoffrey Shouse,Izidore S. Lossos,Juan Pablo Alderuccio
-
Cover Image
Cover Image
![issue cover]()
Blood smear of chronic lymphocytic leukemia, analyzed by microscopy. ID 118071357 © Jarun011 | Dreamstime.com.
Advertisement intended for health care professionals
Advertisement intended for health care professionals